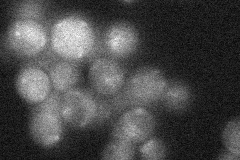
YLR234W
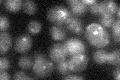
YLR234W

View description
DNA Topoisomerase III, conserved protein that functions in a complex with Sgs1p and Rmi1p to relax single-stranded negatively-supercoiled DNA preferentially, involved in telomere stability and regulation of mitotic recombination
Localization:
Intensity:
Fold change:
Significance:
-
C’ GFP library in SD

nucleus19.8 -
N' NOP1pr-GFP in SD

cytosol34.9123 -
N' TEF2pr-mCherry in SD

nucleus24.3342 -
N' NATIVEpr-GFP in SD
below threshold19.8962 -
N' TEF2pr-VC and Cyto-VN in SD

#N/A0 -
C’ GFP library in SD+DTT

nucleus21.981.11No -
C’ GFP library in SD+H2O2
nucleus19.861No -
C’ GFP library in Starvation Media

nucleus21.381.07No -
C’ GFP library on the background of Pup2-DaMP

nucleus -
C’ GFP library on the background of CCT mutant

nucleus20.27441.02377No
